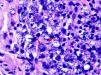

En pacientes con SIDA y leishmaniasis visceral ha sido descrita la presencia de amastigotes de Leishmania en biopsias realizadas para estudiar diversas lesiones con las que no guardan aparente relación causal. Presentamos el caso de un varón de 40 años, VIH positivo severamente inmunodeprimido, en el que se observó incidentalmente la presencia del parásito al estudiar histológicamente un carcinoma epidermoide perianal. Dicho hallazgo permitió el diagnóstico y tratamiento de una leishmaniasis visceral insospechada. No hemos encontrado en la literatura ejemplos previos de esta asociación.
Amastigotes of the genus Leishmania have been observed in biopsies of apparently unrelated lesions in patients with AIDS and visceral leishmaniasis. We describe the case of a 40-year-old man with human immunodeficiency virus infection and severe immunodepression in whom the presence of the parasite was detected as an incidental finding on histological study of a perianal squamous cell carcinoma. This finding led to the diagnosis and subsequent treatment of previously unsuspected visceral leishmaniasis. In a review of the literature we have found no previous examples of this association.
La presencia de amastigotes de Leishmania en biopsias realizadas para estudiar lesiones con las que no guardan aparente relación causal ha sido descrita en pacientes con sida y leishmaniasis visceral1,2. Presentamos un caso en el que se observó la presencia de este parásito en un carcinoma epidermoide perianal. Esta asociación no ha sido descrita hasta el momento en la literatura.
Caso clínicoVarón homosexual de 40 años, VIH positivo en tratamiento con antirretrovirales desde 2005 (abacavir, etravirina y raltegravir), que había sido remitido a nuestro servicio en repetidas ocasiones por condilomas perianales que se trataron con crioterapia. En abril de 2010 fue remitido de nuevo por aparición de una placa erosiva perianal, eritematosa y verrugosa, de meses de evolución (fig. 1). Se decidió realizar una biopsia para descartar transformación maligna.
El estudio histopatológico mostró una epidermis con acantosis marcada, queratinocitos pleomórficos y presencia de mitosis atípicas, confirmando la sospecha clínica de carcinoma epidermoide (fig. 2). En la dermis se identificaron numerosos amastigotes de Leishmania tanto en el interior de los macrófagos como en la matriz intercelular (fig. 3). Se realizó un estudio de hibridación in situ en el que se observó positividad nuclear intensa y multifocal para papilomavirus humano (HPV) de alto riesgo. El estudio inmunohistoquímico mostró positividad para p16 en las áreas neoplásicas.
Al rehistoriar al paciente, este refirió que su perro había muerto 4 años antes a consecuencia de una leishmaniasis. Además, aunque su lugar de residencia habitual era Valencia, viajaba frecuentemente a Marruecos por motivos laborales.
Se solicitaron análisis en los que destacaba un recuento de linfocitos CD4 de 90/mm3 con una carga viral VIH indetectable (<20 cp/ml) y VSG 116mm/h. Los leucocitos totales y las plaquetas eran normales y tan solo existía una anemia leve (hemoglobina 11,9g/dl).
Ante la negativa del paciente a la realización de un estudio de médula ósea, el Servicio de Enfermedades Infecciosas instauró tratamiento empírico con antimoniato de meglumida (20mg/kg/día de antimonio pentavalente durante 28 días). Por otro lado, se programó la extirpación de la lesión maligna. En el estudio histológico de la pieza quirúrgica se volvió a constatar la presencia de Leishmania, a pesar de haber completado ya el tratamiento antimonial. El paciente aceptó esta vez la realización de estudio de médula ósea en el que pudo objetivarse su afectación, confirmándose el diagnóstico de leishmaniasis visceral. Ante estos hallazgos se instauró tratamiento con anfotericina B liposomal. Dado que persistían niveles de CD4 inferiores a 200/mm3, una vez completado el tratamiento se inició quimioprofilaxis secundaria con administración mensual de anfotericina B liposomal. Tras nueve meses de seguimiento, el paciente no ha desarrollado ningún signo clínico ni analítico de leishmaniasis visceral, y sigue actualmente controles regulares por parte del Servicio de Enfermedades Infecciosas.
DiscusiónLas leishmaniasis son debidas a la infección por protozoos del género Leishmania, transmitidos por hembras de mosquitos Phlebotomus y Lutzomya, que parasitan el sistema monocito-macrófago en forma de amastigotes. En nuestro medio, el principal reservorio lo constituyen los perros3 y la especie implicada es la Leishmania infantum4.
En los pacientes inmunodeprimidos, existe un alto riesgo de desarrollar leishmaniasis visceral tras la picadura de un vector infectado3. Aunque tradicionalmente la mayor parte de leishmaniasis visceral se diagnosticaba en los niños, en la actualidad la mayoría de los casos se da en adultos (70%) y de estos el 50% son VIH positivos4,5. En España y el suroeste europeo se encuentra la mayor prevalencia mundial de co-infección, siendo los usuarios de drogas por vía parenteral el grupo de mayor riesgo1–6.
La co-infección por VIH y Leishmania favorece el desarrollo de ambas infecciones. En la respuesta inmunitaria al parásito es fundamental el papel de los linfocitos T CD4 de fenotipo Th1, que se encuentran mermados en los pacientes infectados por VIH, por lo que el riesgo de desarrollar leishmaniasis visceral aumenta de 100 a 2.300 veces, y empeora su evolución y su respuesta al tratamiento4,6. Por otro lado, se ha objetivado una mayor replicación de VIH en presencia de amastigotes de Leishmania, con un empeoramiento del estado inmunitario y una mayor progresión a sida6.
En el contexto de una leishmaniasis visceral en paciente infectado por VIH puede aparecer diseminación cutánea con mayor frecuencia que en inmunocompetentes2 existiendo una gran heterogeneidad clínica en las lesiones1,4,7. Pero además, se han publicado casos de presencia de Leishmania en biopsias de procesos cutáneos no causados por el parásito como sarcoma de Kaposi, dermatofibromas, psoriasis, aftas bucales, herpes simple, herpes zóster, angiomatosis bacilar, tatuajes o nódulos reumatoides1,2.
En nuestro paciente el hallazgo fue incidental al biopsiar un carcinoma epidermoide perianal. No hemos encontrado descrita esta asociación en la literatura. No parece que el parásito sea el responsable del epitelioma, que guardaría relación con la infección crónica por HPV. Su presencia se debe probablemente a una diseminación masiva del parásito en un paciente severamente inmunodeprimido. La existencia de una inflamación local debida al proceso tumoral, con presencia de abundantes histiocitos en el contexto de un sistema mononuclear fagocítico intensamente parasitado, explicaría el hallazgo de abundantes amastigotes en el estudio histológico1,4,8. En nuestro paciente, este hallazgo cutáneo llevó a un estudio más extenso que permitió detectar una afectación visceral insospechada y proporcionar un tratamiento sistémico adecuado, como ha ocurrido en algún otro caso publicado2.
En conclusión, presentamos el primer caso de asociación entre Leishmania y carcinoma epidermoide. En aquellos pacientes VIH positivos que presenten Leishmania en una biopsia cutánea se debe sospechar una leishmaniasis visceral subyacente y parece indicado realizar un estudio de médula ósea, ya que su afectación va a condicionar el tratamiento y, finalmente, el pronóstico2,4.
Conflicto de interesesLos autores declaran no tener ningún conflicto de intereses.